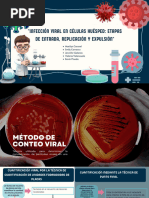

0% encontró este documento útil (0 votos)
50 vistas1 páginaAlgoritmo Secuencial
El documento presenta un algoritmo secuencial desarrollado por la estudiante Valenzuela Suarez Valeria Lissette. Se enfoca en la estructura y funcionamiento del algoritmo. No se proporcionan detalles adicionales sobre su aplicación o resultados.
Cargado por
valenzuelasuarezvDerechos de autor
© © All Rights Reserved
Nos tomamos en serio los derechos de los contenidos. Si sospechas que se trata de tu contenido, reclámalo aquí.
Formatos disponibles
Descarga como PDF, TXT o lee en línea desde Scribd
0% encontró este documento útil (0 votos)
50 vistas1 páginaAlgoritmo Secuencial
El documento presenta un algoritmo secuencial desarrollado por la estudiante Valenzuela Suarez Valeria Lissette. Se enfoca en la estructura y funcionamiento del algoritmo. No se proporcionan detalles adicionales sobre su aplicación o resultados.
Cargado por
valenzuelasuarezvDerechos de autor
© © All Rights Reserved
Nos tomamos en serio los derechos de los contenidos. Si sospechas que se trata de tu contenido, reclámalo aquí.
Formatos disponibles
Descarga como PDF, TXT o lee en línea desde Scribd